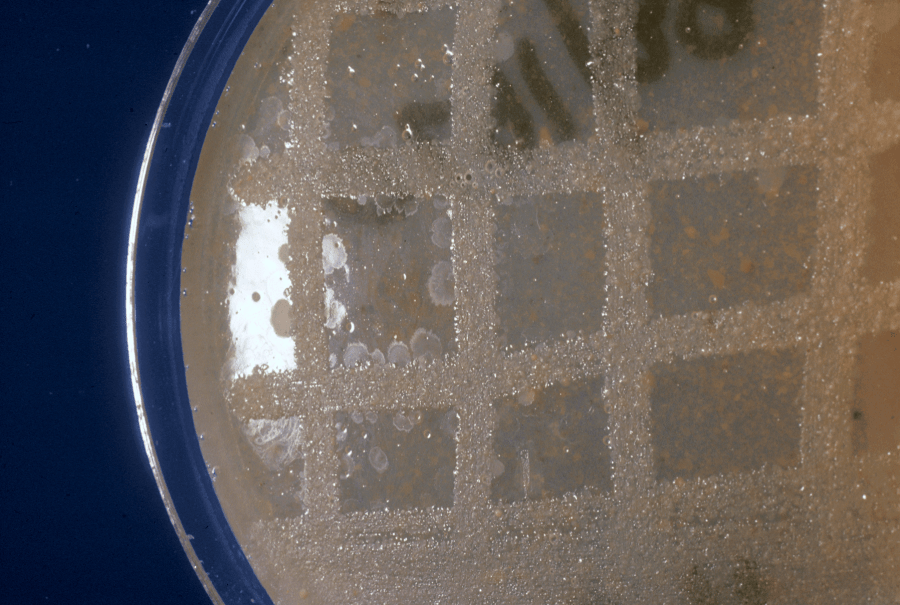

D. nodosus is strictly anaerobic and on 4% hoof agar the colonies are 0.5-1 mm diameter after 5 days with a raised, convex, translucent centre etched into the agar and a flatter, ground-glass periphery with a fimbriate edge (Egerton and Parsonson, 1966). Virulent isolates tend to produce fimbriate spreading colonies with beaded centres while benign isolates tend to produce non-fimbriate colonies with a smooth central dome (Thorley, 1976; Short et al., 1976; Skerman et al., 1981; Stewart et al., 1986b).
Culture must be undertaken before some of the other laboratory tests.
Figure 1. A swab is used to collect a sample from the skin horn junction of an interdigital lesion (Score 1 or 2) (left) or the active margin of underrun lesion (Score 3 or 4) (right) and then used to inoculate a culture plate. Photos: John Egerton

Figure 2. The culture plates are incubated in a sealed jar after removal of oxygen. The culture plates have a layer of solid agar which contains dried sheep hoof. Photo: Ian Links
Figure 3. D. nodosus grows on the surface of the agar and becomes visible after about 5 days. It appears as a faint colony that gradually spreads away from the grid line of the inoculum that was applied to the plate. Each colony is shaped like an ear, and the surface of the colony resembles ground glass. Photo: Ian Links
Go back to: Introduction to lab confirmation